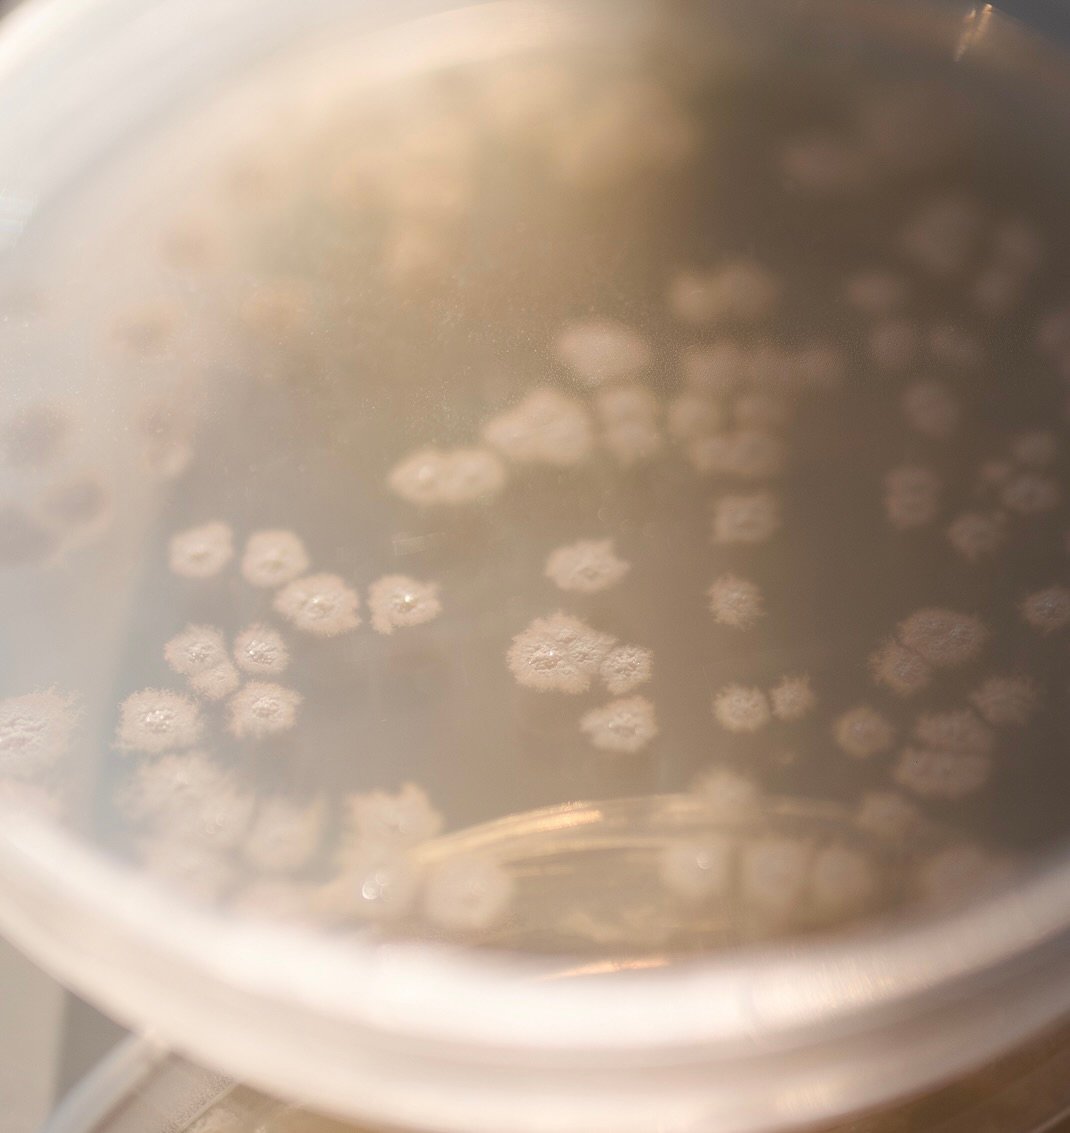

Itin koncentruotas levandų kvapo skalbimo skystis su probiotikais, skirtas visos šeimos rūbų priežiūrai. Pagamintas iš natūralios kilmės, ekologiškų, tarpusavyje tinkamai suderintų žaliavų. Skalbimo priemonė su probiotinėmis bakterijomis užtikrina skalbiamų audinių, skalbimo mašinų bei nuotekų sistemų kvapų kontrolę ir subalansuoja mikrobiologinę aplinką.
- Patikrinta dermatologų ir alergologų
- Be dažiklių, fosfatų, chloro junginių ar sintetinių medžiagų
- Tinka visų tipų audiniams (taip pat šilkui ir vilnai)
- Tinka baltiems ir spalvotiems audiniams
- Galima skalbti įvairiose temperatūrose rankomis ar skalbyklėje
- Tinka namams su biologiniais valymo įrenginiais
- Pakuotės užtenka iki 50 skalbimų
Naudojimas: visą skalbinių tūrį galite skalbti žemiausioje temperatūroje. Esant infekcinėms ligoms rekomenduojama 60°C temperatūra. Mažai užterštiems audiniams naudokite 30ml skalbimo skysčio, daugiau užterštiems – 40ml skalbimo skysčio, o labai užterštiems audiniams – 50ml skalbimo skysčio.
| Kiekis | Vnt. kaina | Nuolaida |
|---|---|---|
| 2-3 | 5,75 € | 4% |
| 4-5 | 5,51 € | 8% |
| 6+ | 5,27 € | 12% |
Papildoma informacija
| Svoris | 1,67 kg |
|---|---|
| Prekinis ženklas | |
| Paskirtis | |
| Kiekis | |
| Panaudojimo ciklai |
50 kartų |
| Pridėtinis kvapas |
Yra |
Liko 314
Pro Biotic
„Lietuvos metų gaminys 2017” aukso medalio laimėtojas.
Pagamintas iš natūralios kilmės, ekologiškų, tarpusavyje tinkamai suderintų žaliavų. PROBIOTIC koncentruotas skalbimo skystis spalvotiems audiniams ne tik efektyviai skalbia, bet ir neleidžia atsirasti nemaloniems kvapams skalbimo mašinoje. Sudėtyje esantys probiotikai akimirksniu praturtina natūralią mikroflorą, suteikia papildomą apsaugą nuo patogeninių bakterijų dauginimosi.


Pristatome per 3 - 5 darbo dienas

Pristatome visoje Lietuvoje

Nemokamas pristatymas

Prekės pristatymos krujeriu
Kodėl probiotikai?
Probiotikai yra mūsų prekės ženklo esmė. Mūsų prekės ženklas buvo sukurtas šių nuostabių gamtos būtybių garbei.
Kas yra probiotikai? Probiotikai, dar vadinami gerosiomis bakterijomis, yra gyvi mikroorganizmai, kurie natūraliai randami tiek žmogaus organizmo viduje, tiek išorinėje, mus supančioje aplinkoje.
Probiotikų svarba mūsų gyvenime. Moksliniais tyrimais įrodyta, kad probiotikai yra naudingi žmogaus sveikatai, teigiamai veikia žarnyno mikrofloros pusiausvyrą, apsaugo organizmą nuo žarnyno blogųjų bakterijų, stimuliuoja imuninę sistemą, padeda greičiau pasveikti.
Kai trūksta gerųjų bakterijų. Įvairūs veiksniai, tokie kaip senėjimas, stresas, ligos, antibiotikų ar kitų vaistų vartojimas, blogi mitybos įpročiai ir žalingos aplinkos sąlygos, gali sumažinti gerųjų bakterijų kiekį organizme. Dėl to gali sutrikti žarnyno veikla, užkietėti viduriai, kilti įvairių infekcijų ir ligų pavojus. Kai gerųjų bakterijų trūksta mūsų organizme, jų galime papildyti vartodami fermentuotus maisto produktus ar probiotinius maisto papildus. Kartais gerųjų bakterijų pritrūksta ne tik mūsų organizmams, bet ir namams, kuriuose gyvename.

Probiotikai neleidžia plisti blogosioms bakterijoms
Jūsų namai taip pat gali sirgti! Įprastos cheminės valymo priemonės ne tik teršia namus pavojingomis cheminėmis medžiagomis, bet ir veikia kaip antibiotikai, t. y. sunaikina ne tik blogąsias, bet ir gerąsias bakterijas namuose, pažeidžia mikrofloros pusiausvyrą – atsiranda bakterijų disbalansas, ima vyrauti blogosios bakterijos. Tokia namų aplinka gali būti žalinga ir pavojinga Jums ir Jūsų šeimai.
Kaip švariai ir saugiai valyti namus? Norint išvalyti namus neteršiant jų pavojingomis cheminėmis medžiagomis, galima naudoti natūralias priemones iš gamtos: actą, sodą, citrinų rūgštį ir pan. Bet vargu ar bus taip švaru, kaip norėtume. Kita išeitis – valyti namus natūraliomis, ekologiškomis valymo priemonėmis. Tačiau ar tai užtikrins švarią ir sveiką namų aplinką? Vien natūralių ir ekologiškų priemonių nepakanka, reikalinga papildoma pagalba iš gamtos – PROBIOTIKAI.











